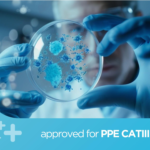

NITRILE BLUE GLOVES S/M/L/XL 10X100 (1000Pcs)
TODENT Nitrile Gloves 10x100pcs are engineered to provide premium hand protection for a wide range of applications. Crafted from high-quality nitrile material, these gloves are both latex-free and powder-free, making them suitable for individuals with sensitive skin or allergies.
Collection Price: £39.99
Delivery Price: £41.99
SKU:
FR-257
Category: CLEANING AIDS